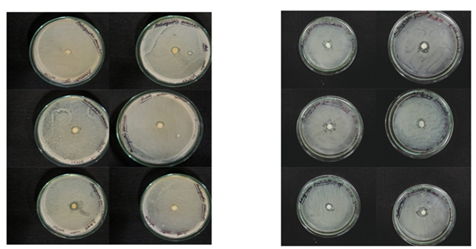

Phytochemical analysis of Andrographis paniculata leaf for their antibacterial and antioxidant potential
Rojina Khatun 1
, Sudeshna Sengupta 1![]()
, Malavika Bhattacharya 2![]()
![]()
1 Research
Scholar, Department of Biotechnology, Techno India University, Kolkata, West
Bengal, India
2 Associate
Professor, Department of Biotechnology, Techno India University, Kolkata, West
Bengal, India
|
|
ABSTRACT |
||
|
Background: Andrographis Paniculata, a herbaceous plant of the Acantharean family, is referred to as the "king of bitters" and is rich in bioactive chemicals. Andrographis Paniculata is a medicinal plant that has been used for many years in traditional medicine. Numerous bioactive substances found in the plant, including polyphenols, flavonoids, and diterpenoids, are responsible for its wide range of pharmacological effects. To assess the antibacterial and antioxidant activity of Andrographis Paniculata leaf extracts, a thorough phytochemical investigation was carried out in this work. Often referred to as the "king of bitters," Andrographis paniculata is a medicinal plant that has been used for many years in traditional medicine. Numerous bioactive substances found in the plant, including polyphenols, flavonoids, and diterpenoids, are responsible for its wide range of pharmacological effects. Aims: This study aimed to investigate the phytochemical composition of Andrographis Paniculata leaves and evaluate their potential antibacterial and antioxidant activities. Materials and Methods: The leaves of Andrographis Paniculata were collected, dried, and subjected to sequential extraction using various solvents including methanol, ethanol, and water. The phytochemical composition of the extracts was determined through qualitative and quantitative analyses to identify the presence of flavonoids, tannins, flavanols, and polyphenols. The antibacterial potential of Andrographis Paniculata, leaf extracts was assessed against six pathogenic bacteria including both gram positive and gram-negative strains by determining minimum inhibitory concentration and zone of inhibition. The extracts inhibited the growth of these bacteria and also induced bacterial cell death. Zone of inhibition values were compared with control in concentration 20 mµg /ml. Result: The growth of both Gram-positive and Gram-negative bacteria is inhibited by the ethanol extract. The antioxidant ability of leaf extracts was evaluated using assays such as 2, 2-diphenyl-1-picrylhydrazyl (DPPH), and vitamin C. The results show that when oxidized, the DPPH produces a persistent purple radical. Conclusion: Andrographis paniculata leaf extracts have been shown in this study to have excellent antibacterial and antioxidant properties, highlighting the plant's therapeutic value as a source of naturally occurring bioactive chemicals. These results add to the increasing amount of data that supports the traditional medicine practice of using Andrographis paniculata and shed light on the uses of the plant in the creation of new antioxidant and antibacterial agents. |
|||
|
Received 06 May 2024 Accepted 10 June 2024 Published 26 July 2024 Corresponding Author Malavika Bhattacharya, malavikab@gmail.com DOI 10.29121/IJOEST.v8.i4.2024.623
Funding: This research
received no specific grant from any funding agency in the public, commercial,
or not-for-profit sectors. Copyright: © 2024 The
Author(s). This work is licensed under a Creative Commons
Attribution 4.0 International License. With the
license CC-BY, authors retain the copyright, allowing anyone to download,
reuse, re-print, modify, distribute, and/or copy their contribution. The work
must be properly attributed to its author.
|
|||
|
Keywords: Bioactive
Compounds, Medicinal Plant, Natural Antioxidants, Traditional Medicine |
|||
1. INTRODUCTION
Andrographis paniculata, commonly known as the “king of bitters, “is a native plant to Southeast Asia that has medicinal properties. It is a member of the Acanthaceae family and has been used for generations in Chinese and traditional Ayurvedic medicine. With little white flowers and lance-shaped leaves, the plant has a sturdy stature Jean & Bokelmann (2022). The medicinal qualities of Andrographis Paniculata are attributed to a wide variety of bioactive substances it contains, such as polyphenols, flavonoids, and diterpenoids. Andrographolide is the most important bioactive molecule; it has strong anti-inflammatory, antioxidant, and immune-stimulating properties. Moreover, it demonstrates hepatoprotective, antiviral, antibacterial, and antimalarial properties Intharuksa et al. (2022). The plant’s possible medical uses have been thoroughly investigated. Because of its immune-stimulating and antiviral qualities, studies have demonstrated that Andrographis Paniculata can effectively treat respiratory infections, including the common cold, the flu, and bronchitis. Additionally, it has shown encouraging anti-cancer properties in a number of preclinical and clinical investigations. Furthermore, studies on Andrographis Paniculata have revealed hepatoprotective properties, which mean that it is good for liver health Li et al. (2023). Research has demonstrated the strong anti-inflammatory, antioxidant, and immune-stimulating qualities of Andrographis Paniculata. Numerous illnesses, including fever, digestive issues, liver diseases, respiratory infections, and skin conditions have all been treated and prevented with it. Additionally, the plant has demonstrated antibacterial efficacy against a variety of diseases, including as viruses, bacteria, and fungi. Furthermore, Andrographis Paniculata has shown encouraging promise in the anticancer drug field. Studies have revealed that the herb has pro-apoptotic anti-proliferative properties against cancer cells, especially those from the prostate, colorectal, lung, and breast malignancies Sadhana et al. (2020). It is important to remember that while though regarded as safe when taken as directed; some people may experience moderate adverse effects like gastrointestinal problems or allergic responses. It is recommended that you speak with a medical expert before using any herbal supplement. In conclusion, Andrographis Paniculata is a remarkable medicinal herb with a long history of application in conventional medicine. Owing to extensive research on its therapeutic qualities, it is being utilized as a natural remedy for a variety of ailments. It is still a viable choice for integrative and alternative medicine, but its full potential has to be explored Shahid (2020).
1.1. Significance of Andrographis Paniculata
Because of all of its therapeutic uses, Andrographis paniculata, also called the ‘ king of Bitters’, is an extremely important herbal plant. It is indigenous to South Asian nations and has long been utilized in traditional medicine Bhaisare et al. (2023). Andrographis paniculata is important because it contains strong bioactive substances, including andrographolides. Because of these chemical’s numerous health benefits, this herb is a crucial part of many traditional treatments. Andrographis pediculate’s ability to strengthen immunity is one of its main applications. By strengthening the body’s defences against bacterial and viral infections, it helps prevent these conditions. Research has indicated that it may be useful in treating and preventing colds, the flu, and respiratory infections Raman et (2022).
Additionally, Andrographis paniculata possesses antioxidant and anti-inflammatory properties. It can lessen the symptoms of inflammatory diseases like arthritis by preventing the synthesis of pro-inflammatory chemicals. Its antioxidant properties also aid in preventing damage from free radicals and oxidative stress. The plant has hepatoprotective qualities that support liver cleansing and liver health. It may also assist in controlling blood sugar levels, which is advantageous for those who have diabetes Jadhav & Karuppayil (2021).
Andrographis paniculata has anticancer that may be able to stop some cancer cell types from growing. Andrographis paniculata is a noteworthy and adaptable herb with a variety of acknowledged as a significant herbal treatment due to its hepatoprotective, anti-inflammatory, antioxidant, and immune-boosting properties. Chauhan et al. (2019).
1.2. Goals for the research
The main goals of this research are to –
· Analyse the phytochemical composition of A.paniculata leaf extracts.
· Evaluate the antioxidant potential A.paniculata leaf extracts.
· Investigate the antibacterial activity of A.paniculata leaf extracts against selected six bacterial strains.
2. MATERIAL AND METHODS
2.1. Plant collection
At the Acharya Jagadish Chandra Bose Indian Botanic Garden in Howrah, West Bengal, fresh leaves of Andrographis paniculata were collected from trees that were growing naturally.
The healthy leaves were separated, properly cleaned with sterile water, and then arranged on trays made of clean mesh to dry. For a week, the leaves were kept in the shade. The leaves were powered by an electrical mixer after they had dried. The finely ground sample was placed in an airtight glass jar to retain its phytochemical and antibacterial properties Kasemsumran et al. (2021).
2.2. Extraction processes
Firstly take the power sample in a falcon tube and add 10 ml of 70% ethanol. The ratio of solvent to plant material 1:5 and 1:10 ratio is used. Ensure that the plant material is completely submerged in the solvent. Seal the container tightly and let it stand for 24 hours, allowing the ethanol to extract the desired compounds from the plant material. During this time, the mixture should be stirred occasionally to enhance extraction efficiency. After that, the mixture needs to be filtered to remove the solid plant material by a funnel with filter paper. This step helps separate the ethanol extract from the plant material residue. After filtration, the ethanol extract is collected in a separated container and subjected to concentration. Evaporation under reduce pressure using rotary evaporators is a common method for concentrating the extract. The ethanol is evaporated, leaving behind a concentrated extract of Andrographis paniculata Rafi et al. (2020).
2.3. Phytochemical Analysis
· Qualitative Analysis of phytoconstituents:
To determine whether a particular plant extract contains any of the many kinds of compounds originating from plants or secondary metabolites, the phytochemical screening approach is frequently employed. Phytochemical screening was applied to this specific portion of the A. paniculata dry extract. Numerous kinds of phytochemicals were evaluated during the screening process, including flavonoids, tannins and polyphenols. A number of chemicals assays unique to each type of phytochemical were used in the screening procedure Bachhar et al. (2023), Archana & Geetha Bose (2022).
·
Estimation of Flavonoids:
Principle:
Plants include a family of chemicals called flavonoids, which have a variety of biological actions as their secondary metabolites. The colorimetric concept, which states that the concentration of flavonoids is directly correlated with the intensity of colour created, is used to estimate the flavonoid content in a sample. The aluminum chloride colorimetric test is a frequently employed technique for this purpose. In this test, a spectrophotometer is used to detect the colour complex that is created when an aluminium ion and chelating agent react at a wavelength of 510 nm There is a direct relationship between the intensity of the colour and the quantity of aluminium ions in the sample Niran et al. (2023).
·
Estimation of Polyphenols:
Principle:
The Folin-Ciocalteu colorimetric method is a commonly employed technique for determining the overall polyphenol content of a given specimen. The fundamental concept behind the Folin-Ciocalteu method is that phenolic groups in polyphenols lower the reagent in an alkaline environment. The reaction produces a complex that has a blue hue, and the intensity of the complex is directly linked to the overall polyphenol content of the sample Vingrys et al. (2023).
·
Estimation of Tannins:
Principle:
Tannins have the ability to lower the Folin-Ciocalteu reagents, which results in the complex's development of a blue color. The amount of tannins contained in the sample is directly correlated with the color's intensity. The tannin content can be assessed by measuring the complex's absorbance at a certain wavelength Sharma et al. (2021).
2.4. Antioxidant Activity
·
Antioxidant activity using the DPPH Method:
Principle:
To assess a compound's antioxidant activity, the 2,2-diphenyl-1-picrylhydrazyl (DPPH) method is commonly used. The fundamental concept of the assay is that antioxidants and the stable free radical DPPH interact by trading hydrogen atoms, which results in a colour shift that can be detected using a spectrophotometer from purple to yellow Ngueumaleu et al. (2023).
·
Estimation of Vitamin C by Titration Method:
Principle:
Ascorbic acid, or vitamin C, is estimated using a redox titration method. Using this technique, the ascorbic acid in the sample is oxidized to dehydroascorbic acid by an oxidizing agent, such as iodine. Then, using a standardized solution of a reducing agent, such as sodium thiosulfate, to titrate, the amount of oxidizing agent eaten is determined. The endpoint of the titration is determined by using a starch indicator, which becomes blue-black in the presence of excess iodine Carr et al. (2022).
The ascorbic acid level in a sample can be quantitatively measured using the titration method for vitamin C estimate, which is useful for assessing the nutritional value and quality control of food products. This method is widely used in the food industry, research laboratories, and medical settings to quantify the amount of vitamin C contained in various samples. Reliable vitamin C estimation results depend on precise titration techniques and cautious reagent management Sufitri et al. (2023).
2.5. Antibacterial Activity
·
Antibacterial Activity by Disc Diffusion
Method:
Principle:
The antibacterial qualities of the samples are allowed to seep into the media and interact with freshly seeded test organisms on a plate. The result will be consistently circular zones of inhibition with a confluent lawn of growth. One can measure the diameter of the zone of inhibition in millimeters. The agar used is called Nutrient agar for bacteria, and its composition and pH have undergone extensive testing. Standard zones of inhibition have been established for sensitive and resistant values in this well-documented approach. Additionally, there is a zone of intermediate resistance, which suggests that although this antimicrobial inhibits the organism to some extent; it may not be enough to completely remove it from the body Harbade et al. (2020).
Test organisms:
The bacterial strains used for the antibacterial activity test were obtained from Techno India University, Kolkata West Bengal.
1) Escherichia coli
2) Staphylococcus aureus
3) Bacillus anthaacis
4) Staphylococcus epidermidis
5) Enterobacter aerogenes
6) Klebsiella pneumonia
3. RESULTS
3.1. Phytochemical Analysis
Through qualitative analysis of the tested extracts, the presence of phytochemicals such as tannins, polyphenols, and flavonoids was identified. Tannic acid was present in both the ethanol and water extracts. Flavonoids are present in both ethanol and water-based extracts. The water extracts did not contain polyphenol, while the ethanol extracts did.
An overview of the phytochemical analysis results discovered in water and ethanol extracts is shown in Table 1.
Table 1
|
Table 1 Primary Phytochemicals Identified in Leaf Extracts of Andrographis Paniculata |
||
|
Phytoconstituents |
Extracts of Organic Solvents |
|
|
|
Ethanol Extract |
Aqueous Extract |
|
Flavonoids |
+ |
+ |
|
Tannin |
+ |
+ |
|
Polyphenols |
+ |
_ |
|
+ (Present), - (Absent) |
||
Figure 1
|
Figure 1 A. Ethanol Extract of Flavonoid |
Figure 2

|
Figure 2 B. Water Extract of Flavonoid |
Figure 3

|
Figure 3 A. Ethanol Extract of Tannin |
Figure 4

|
Figure 4 B. Water Extract of Tannin |
Figure 5

|
Figure 5 A. Ethanol Extract of Polyphenol |
3.2. Antioxidant Activity
3.2.1. Antioxidant activity by DPPH Method
A concentration of 500 µg m to 100 µg m was prepared by diluting the tested extract. 2,2-diphenyl-1-picrylhydrazyl (DPPH) free radical scavenging activity was determined in the solvent fractions. The range of recorded inhibition percentages was 24.25 to 64.6. The data for the solvent fractions are summarized in Table 2.
Table 2
|
Table 2 A. Paniculata Leaf Extract's Antioxidant Capacity |
|||||
|
Solvent Fractions |
Concentrations of Extracts (µg ml-¹) |
||||
|
100 |
200 |
300 |
400 |
500 |
|
|
Ethanol |
24.25± |
44.2± |
51.2± |
56.6± |
64.6± |
|
3.2 |
3.2 |
1.3 |
4.2 |
2.4 |
|
|
Data represent the
mean ± standard deviation with three replicates (n = 3) |
|||||
3.2.2. Estimation of Vitamin C by Titration Method
The titration method allowed for the successful estimation of vitamin C content in the A. paniculata extract and limcee. This result obtained indicates that the A. Paniculata contains 29.8% of vitamin C and limcee contains 70.2% of vitamin C.
Figure 6

|
Figure 6 A. Paniculata Shows 29.8% Vitamin C Activity in Compared with Limcee |
3.3. Antibacterial Activity
The antibacterial properties of Andrographis paniculata were observed against six different types of bacteria: Enterobacter aerogenes, Bacillus anthracis, Klebsiella pneumonia, Staphylococcus aureus, and Staphylococcus epidermidis. The ethanol extract was most active against klebsiella pneumonia and inactive against E. coli and Bacillus anthracis. The aqueous extract exhibits negligible activity against Bacillus anthracis but high activity against Staphylococcus aureus. As seen by Table 3, Bacillus anthracis exhibits no action against either the ethanol or the aqueous extract.
·
(absent)
Table 3
|
Table 3 The Antibacterial Properties of Andrographis Paniculata's Aqueous and Ethanol Leaf Extract |
||
|
Microorganism’s Name |
Inhibitory Zone |
|
|
|
Water Extract |
Ethanol Extract |
|
Escherichia Coli |
2 |
- |
|
Staphylococcus aureus |
7 |
3 |
|
Bacillus epidermidis |
- |
- |
|
Staphylococcus epidermidis |
1 |
5 |
|
Klebsiella pneumonia |
3 |
8 |
|
Enterobacter aerogenes |
5 |
6 |
|
A. Water Extract B. Ethanol Extract |
4. DISSCUSSION
Phytochemical analysis of Andrographis paniculata leaves has revealed the presence of various bioactive compounds that contribute to its pharmacological properties. The major phytoconstituents identified in the leaves include andrographolide, neo andrographolide, flavonoids, alkaloids, and polyphenols. These compounds are known for their antibacterial and antioxidant potential, making Andrographis paniculata a valuable plant in traditional medicine. Andrographolide, the primary active ingredient of Andrographis paniculata, has been the subject of much research due to its potential antibacterial effects. Both Gram-positive and Gram-negative types of bacteria have been demonstrated to be inhibited by it. Another diterpene lactone included in the leaves, neo andrographolide, has similarly demonstrated antibacterial efficacy against a range of diseases. Moreover, the flavonoids present in Andrographis paniculata leaves, such as andrographolide, have shown antibacterial effects by inhibiting the growth of bacteria. Flavonoids are known for their ability to disrupt bacterial cell membranes and inhibit bacterial enzymes, rendering them effective against bacterial infections. In addition to its antibacterial potential, Andrographis paniculata leaves also possess antioxidant properties due to the presence of polyphenols and alkaloids These substances prevent oxidative damage to cells and tissues by scavenging free radicals. The anti-inflammatory, anti-oxidant properties of Andrographis paniculata leaves also improve cellular function and guard against disorders associated with oxidative stress. Several studies have confirmed the antibacterial and antioxidant potential of Andrographis paniculata leaves, supporting its traditional use in treating various infections and inflammatory conditions. The phytochemical analysis of the plant provides a scientific basis for its therapeutic efficacy and highlights the importance of utilizing natural sources for health benefits Amal & Irfansyah (2023) .
5. CONCLUSION
Phytochemical analysis of Andrographis paniculata leaves has revealed the existence of many bioactive compounds, such as andrographolide, flavonoids, and polyphenols. These compounds possess remarkable antibacterial and antioxidant qualities that may find application in medicine. Because Andrographis paniculata can disrupt important metabolic processes or break down the cell walls of a range of pathogenic bacteria, it is believed to have antibacterial qualities. Because of this, it is a viable option for the synthesis of new antibacterial chemicals that are effective against microbes that are resistant to drugs.
Furthermore, the ability of Andrographis paniculata to scavenge free radicals and reduce oxidative stress in the body is supported by its strong antioxidant properties. Maintaining general health and preventing certain chronic illnesses require this. We can take advantage of Andrographis paniculata leaf extracts' strong antioxidant properties to support health and prevent oxidative damage by adding them to medications or dietary supplements.
Ultimately, the phytochemical examination of Andrographis paniculata leaves highlights their noteworthy capacity against germs and as an antioxidant. To fully investigate the therapeutic effects of this plant and its bioactive substances in treating bacterial infections and disorders associated to oxidative stress, more investigation and clinical studies are necessary.
6. Disclosure
The potential antibacterial and antioxidant qualities of an Andrographis paniculata leaf were assessed using phytochemical analysis. Using a variety of solvents, research participants extracted different substances from the plant's leaves. The study's findings showed that Andrographis paniculata leaves contain a number of bioactive substances, such as flavonoids, flavanols, and tannins which are well-known for their antibacterial and antioxidant qualities. Reports indicate that these chemicals have considerable antioxidant activity and powerful inhibitory effects against a variety of harmful microorganisms. These qualities can shield cells from oxidative damage and reduce the likelihood of chronic illness development Adiguna et al. (2023).
Recalling that the efficacy of Andrographis paniculata leaf extracts in vivo requires additional research, as the study's conclusions are based on in vitro testing, is an important consideration. Also, before using any herbal supplements or therapies that promise to have antibacterial or antioxidant qualities, it is advisable to see a healthcare professional. According to the results of the phytochemical research, the leaf of Andrographis paniculata contains bioactive compounds that may possess antibacterial and antioxidant properties. To ascertain whether these substances have any potential medical use, more research on them is necessary Parihar (2022).
CONFLICT OF INTERESTS
None.
ACKNOWLEDGMENTS
I would like to express my sincere appreciation to Techno India University for providing me with knowledge and guidance required.
First and foremost, I am deeply grateful to my research supervisor Dr. Malavika Bhattacharya for her continuous guidance, support, and inspiration throughout the entire research process. Her expertise and encouragement have been instrumental in shaping the direction of this paper.
I would also like to thank my colleagues Sudeshna Sengupta and Sharmi Bhakta for their valuable feedback, suggestions, and discussions that have helped me refine my ideas and strengthen my arguments.
REFERENCES
Adiguna, S. P., Panggabean, J. A., Swasono, R. T., Rahmawati, S. I., Izzati, F., Bayu, A., Putra, M. Y., Formisano, C., & Giuseppina, C. (2023). Evaluations of Andrographolide-Rich Fractions of Andrographis paniculata with Enhanced Potential Antioxidant, Anticancer, Antihypertensive, and Anti-Inflammatory Activities. Plants (Basel, Switzerland), 12(6). https://doi.org/10.3390/plants12061220
Amal, R. J., & Irfansyah. (2023). The Potential of Andrographis Paniculata as a Supplement for the Management of Benign Prostate Hypertrophy (BPH): A Systematic Literature Review. Eureka Herba Indonesia. https://doi.org/10.37275/ehi.v4i2.70
Archana, H., & Geetha Bose, V. (2022). Evaluation of Phytoconstituents from Selected Medicinal Plants and Its Synergistic Antimicrobial Activity. Chemosphere, 287 (Pt 4). https://doi.org/10.1016/j.chemosphere.2021.132276
Bachhar, V., Joshi, V., Gangal, A., Duseja, M., & Shukla, R. K. (2023). Identification of Bioactive Phytoconstituents, Nutritional Composition and Antioxidant Activity of Calyptocarpus Vialis. Applied Biochemistry and Biotechnology. https://doi.org/10.1007/s12010-023-04640-5
Bhaisare, S., Pathak, S., & Ajankar, V. V. (2023). Physiological Activities of the King of Bitters (Andrographis Paniculata): A Review. Cureus, 15(8). https://doi.org/10.7759/cureus.43515
Bokelmann, J. M. (2022). Andrographis (Andrographis Paniculata). https://doi.org/10.1016/b978-0-323-84676-9.00025-8
Carr, A. C., Block, G., & Lykkesfeldt, J. (2022). Estimation of Vitamin C Intake Requirements Based on Body Weight: Implications for Obesity. Nutrients, 14(7). https://doi.org/10.3390/nu14071460
Chauhan, E. S., Sharma, K., & Bist, R. (2019). Andrographis Paniculata: A Review of its Phytochemistry and Pharmacological Activities. Research Journal of Pharmacy and Technology. https://doi.org/10.5958/0974-360X.2019.00153.7
Harbade, M. S., Iravane, J. A., Kante, S., & Pedwal, N. (2020). Identification of Candida Species and Antifungal Sensitivity Testing by Disc Diffusion Method. International Journal of Current Microbiology and Applied Sciences. https://doi.org/10.20546/IJCMAS.2020.911.292
Intharuksa, A., Arunotayanun, W., Yooin, W., & Sirisa-Ard, P. (2022). A Comprehensive Review of Andrographis paniculata (Burm. f.) Nees and its Constituents as Potential Lead Compounds for COVID-19 Drug Discovery. Molecules (Basel, Switzerland), 27(14). https://doi.org/10.3390/molecules27144479
Jadhav, A. K., & Karuppayil, S. M. (2021). Andrographis Paniculata (Burm. F) Wall ex Nees: Antiviral Properties. Phytotherapy Research: PTR, 35(10), 5365–5373. https://doi.org/10.1002/ptr.7145
Jean, M., & Bokelmann. (2022). Andrographis (Andrographis Paniculata). https://doi.org/10.1016/b978-0-323-84676-9.00025-8
Kasemsumran, S., Apiwatanapiwat, W., Ngowsuwan, K., & Jungtheerapanich, S. (2021). Rapid selection of Andrographis Paniculata Medicinal Plant Materials Based on Major Bioactive Using Near-Infrared Spectroscopy. Chemicke Zvesti, 75(11), 5633–5644. https://doi.org/10.1007/s11696-021-01746-0
Li, J., Liu, X., Li, J., Han, D., Li, Y., & Ge, P. (2023). Mechanism of Andrographis Paniculata on Lung Cancer by Network Pharmacology and Molecular Docking. Technology and Health Care: Official Journal of the European Society for Engineering and Medicine, 31(4), 1407–1427. https://doi.org/10.3233/THC-220698
Ngueumaleu, Y., Deutchoua, A. D.D., Hanga, S.S.P., Liendji, R. W., Dedzo, G. K., & Ngameni, E. (2023). Probing the Reactivity of 2,2-Diphenyl-1-Picrylhydrazyl (DPPH) with Metal Cations and Acids in Acetonitrile by Electrochemistry and UV-Vis Spectroscopy. Physical Chemistry Chemical Physics. https://doi.org/10.1039/d2cp05296b
Niran, A. A.-O., Al-Jaboury, I. S., & Hasan, Z. Y. M. (2023). Qualitative and Quantitative Estimation of Total and Individual Flavonoids from Aerial Parts of Achillia Santolina Grown in Iraq. Research Journal of Pharmacy and Technology, 6(1). https://doi.org/10.52711/0974-360X.2023.00052
Parihar, S. (2022). A Review on Pharmacological Activities of Andrographis Paniculata. Biological Sciences. https://doi.org/10.55006/biolsciences.2022.2106
Rafi, M., Devi, A. F., Syafitri, U. D., Heryanto, R., Suparto, I. H., Amran, M. B., Rohman, A., Prajogo, B., & Lim, L. W. (2020). Classification of Andrographis Paniculata Extracts by Solvent Extraction using HPLC Fingerprint and Chemometric Analysis. BMC Research Notes, 13(1), 56. https://doi.org/10.1186/s13104-020-4920-x
Raman, S., Murugaiyah, V., & Parumasivam, T. (2022). Andrographis Paniculata Dosage Forms and Advances in Nanoparticulate Delivery Systems: An Overview. Molecules (Basel, Switzerland), 27(19). https://doi.org/10.3390/molecules27196164
Sadhana, H. M., Suresh, J., & Hamsalakshmi. (2020). Andrographis Paniculata – A Review. International Journal of Research in Pharmaceutical Sciences, 11(4). http://dx.doi.org/10.26452/ijrps.v11i4.3162
Shahid, A. (2020). Andrographis Paniculata (Burm. f.) Nees. (Acanthaceae). http://dx.doi.org/10.1007/978-3-030-16807-0_26
Sharma, T., Gamit, R., Acharya, R., & Shukla, V. J. (2021). Quantitative Estimation of Total Tannin, Alkaloid, Phenolic, and Flavonoid Content of the Root, Leaf, and Whole Plant of Byttneria Herbacea Roxb. Ayu, 42(3), 143–147. https://doi.org/10.4103/ayu.AYU_25_19
Sufitri, E., Emelda, E., Munir, M.A., & Aprilia, V. (2023). The Detection of Ascorbic Acid in Orange (Rutaceae Sp.) Using Titration Technique. https://doi.org/10.53866/ajac.v1i1.267
Vingrys, K., Mathai, M. L., Apostolopoulos, V., Bassett, J. K., de Courten, M., Stojanovska, L., Millar, L., Giles, G. G., Milne, R. L., Hodge, A. M., & McAinch, A. J. (2023). Estimated Dietary Intake of Polyphenols from Cereal Foods and Associated Lifestyle and Demographic Factors in the Melbourne Collaborative Cohort Study. Scientific Reports, 13(1), 8556. https://doi.org/10.1038/s41598-023-35501-0
This work is licensed under a: Creative Commons Attribution 4.0 International License
© Granthaalayah 2014-2024. All Rights Reserved.